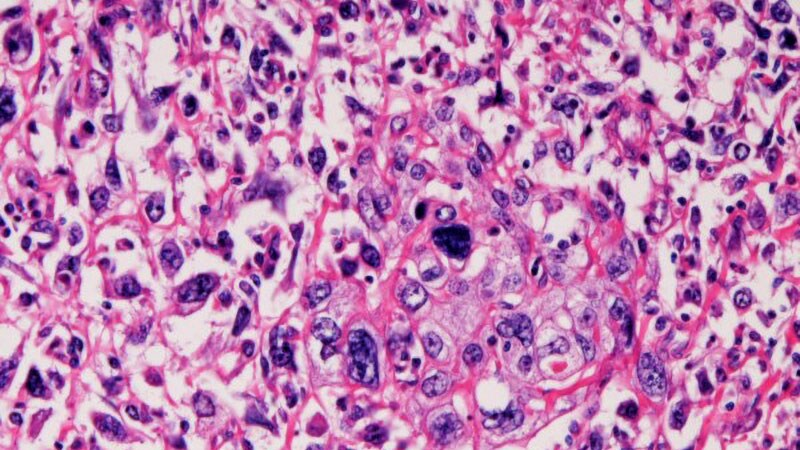
Combo Therapy Hailed as Standard for Urothelial Carcinoma

- Added to Email Alerts
Bladder Cancer
Latest News View All
-
 AlertFDA OKs Enfortumab Vedotin Plus Pembro for Urothelial Cancer
AlertFDA OKs Enfortumab Vedotin Plus Pembro for Urothelial Cancer -
 Choosing the Right Approach to Cancer and Menopause Symptoms
Choosing the Right Approach to Cancer and Menopause Symptoms -
Production of Cancer Drug Cisplatin Resumed Amid Shortages
-
 Combo Therapy Hailed as Standard for Urothelial Carcinoma
Combo Therapy Hailed as Standard for Urothelial Carcinoma -
 We Know Exercise Prevents Cancer. A New Study Tells Us Why
We Know Exercise Prevents Cancer. A New Study Tells Us Why -
 Urine Test Shows Promise for Diagnosing Urothelial Carcinoma
Urine Test Shows Promise for Diagnosing Urothelial Carcinoma -
 ASCO 2023T-DXd Active in Many Solid Tumors; 'Shift in Thinking'
ASCO 2023T-DXd Active in Many Solid Tumors; 'Shift in Thinking' -
 Don't Remove Bladder for Localized Muscle-Invasive Cancer
Don't Remove Bladder for Localized Muscle-Invasive Cancer
Perspective View All
Journal Articles View All
-
Early Mortality in ICI-Treated Cancers in Routine Practice
-
Technologic Advances in Robotic Nephron Sparing Surgery
-
Reflections on Treatment for Endometriosis-associated Pain
-
Impact of Antibiotic Exposure Before ICIs on Cancer Survival
-
Surgical Treatment for Male Stress Urinary Incontinence
-
Diagnosis, Causes, and Treatment of Postmenopausal Dyspareunia